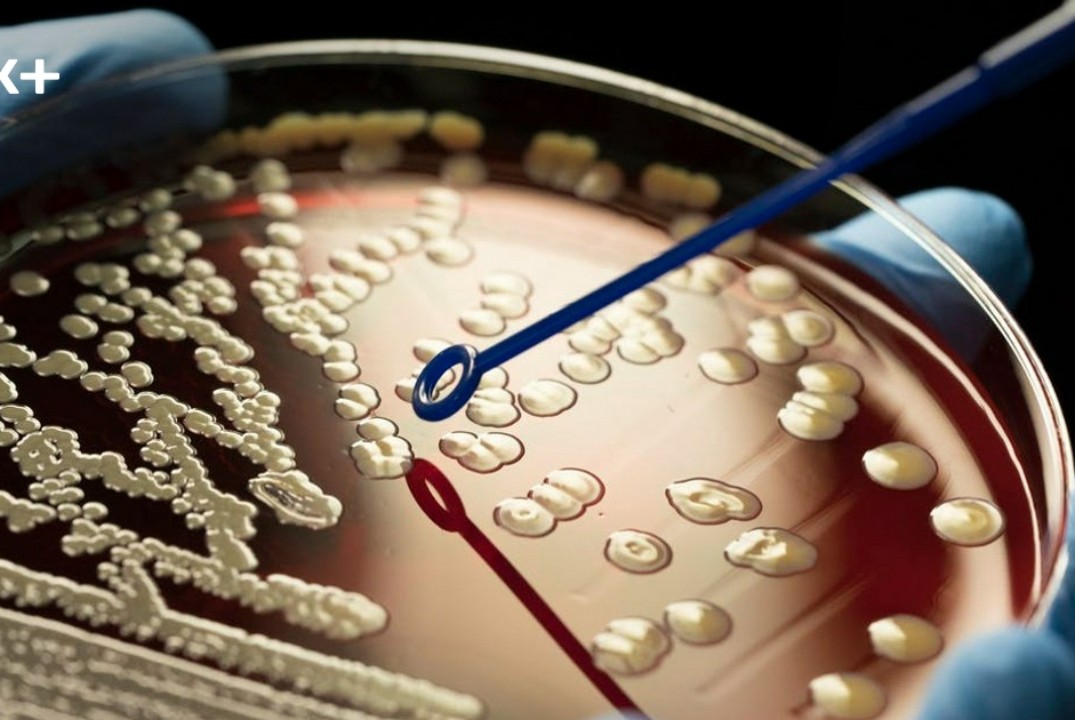
77-ая студенческая научная конференция, секция "Актуальны...

Ольга Валентиновна Селицкая
Селицкая
Ольга
Валентиновна
Опыт работы
Пользователь не заполнил информацию об опыте работы
Образование
Пользователь не заполнил информацию об образовании
Резюме
Пользователь скрыл информацию
Дополнительно
Активность
Интересы
Проекты
Нет проектов для отображения
Команды
Нет команд для отображения